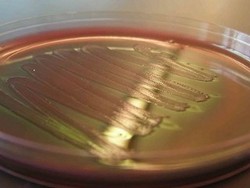
Ada Bakteri yang Bisa Menghasilkan Bensin

detikHealth
Risiko Obesitas dan Sakit Jantung Seseorang Ditentukan Sejak di Rahim
Bukan rahasia umum lagi jika apapun yang dilakukan dan dikonsumsi wanita hamil akan berpengaruh bagi bayinya. Tapi mungkin tak banyak yang tahu jika kecenderungan seseorang untuk mengalami obesitas dan gangguan kesehatan lainnya saat dewasa sudah dapat ditentukan sejak dalam kandungan.
Selasa, 21 Mei 2013 17:00 WIB